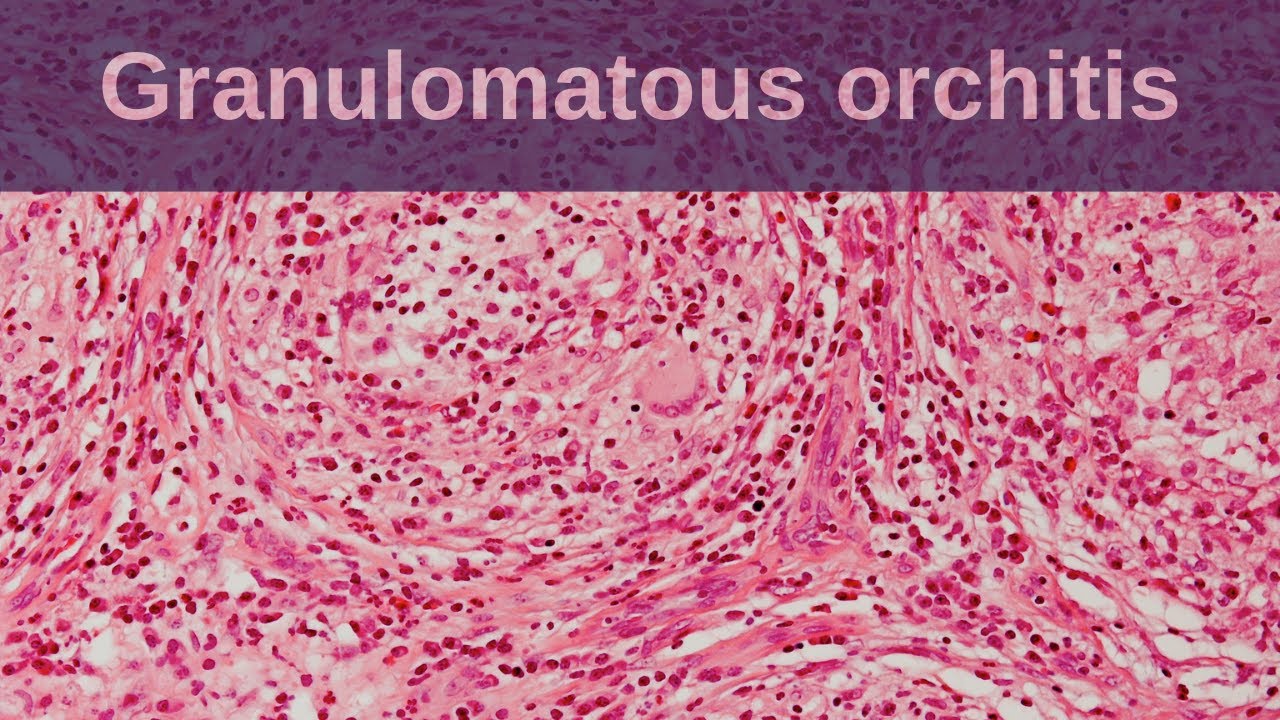
Gross Appearance Of Epididymo Orchitis

Orchitis Rabbit
Enhance your understanding of Orchitis Rabbit with extensive collections of carefully selected educational photographs. enhancing knowledge retention through engaging and informative imagery. encouraging critical thinking and analytical skill development. Discover high-resolution Orchitis Rabbit images optimized for various applications. Excellent for educational materials, academic research, teaching resources, and learning activities All Orchitis Rabbit images are available in high resolution with professional-grade quality, optimized for both digital and print applications, and include comprehensive metadata for easy organization and usage. Our Orchitis Rabbit images support learning objectives across diverse educational environments. The Orchitis Rabbit archive serves professionals, educators, and creatives across diverse industries. Regular updates keep the Orchitis Rabbit collection current with contemporary trends and styles. The Orchitis Rabbit collection represents years of careful curation and professional standards. Reliable customer support ensures smooth experience throughout the Orchitis Rabbit selection process. Advanced search capabilities make finding the perfect Orchitis Rabbit image effortless and efficient. Professional licensing options accommodate both commercial and educational usage requirements. Time-saving browsing features help users locate ideal Orchitis Rabbit images quickly. Whether for commercial projects or personal use, our Orchitis Rabbit collection delivers consistent excellence. Instant download capabilities enable immediate access to chosen Orchitis Rabbit images. Each image in our Orchitis Rabbit gallery undergoes rigorous quality assessment before inclusion.

30042-7/asset/ea2649f9-2360-4efe-b45f-e4aad595b6fa/main.assets/gr3_lrg.jpg)











































































